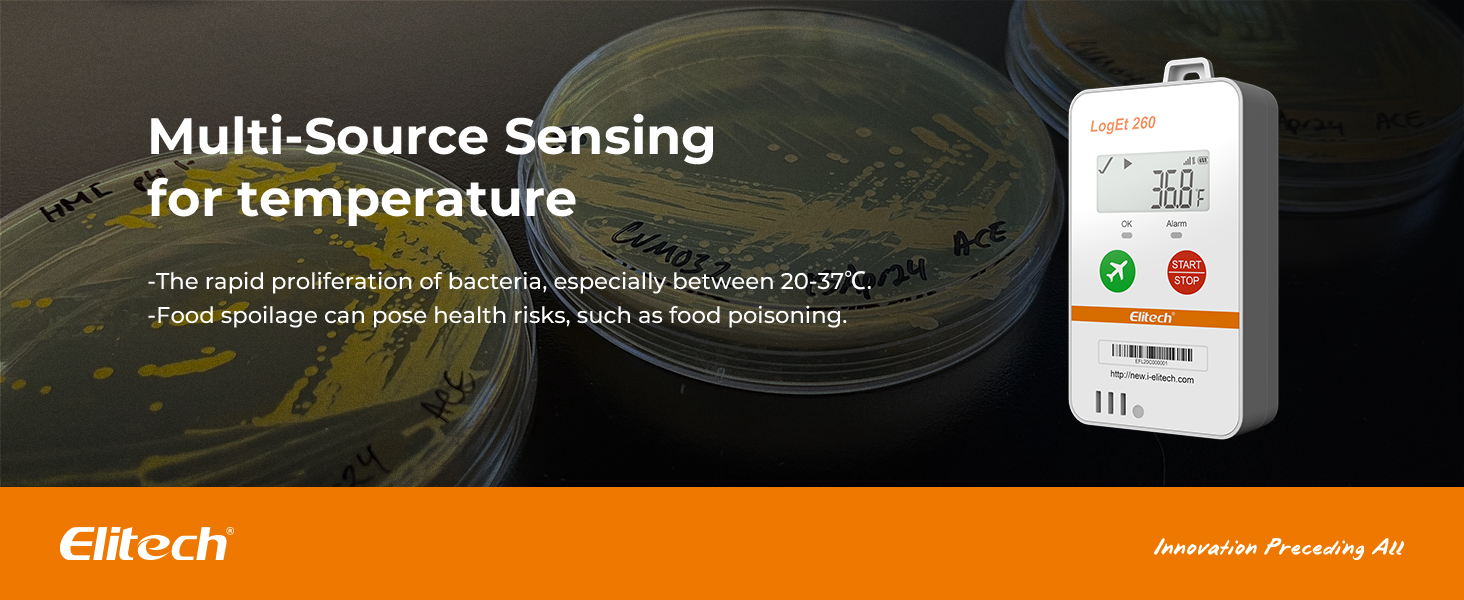

Elitech 4G Reusable Real-time Temperature Humidity Data Logger Light/Shock/Location, Built-in SIM Card, Shadow Data,Airplane Mode,Cloud Data Storage,SMS/Email/APP/Web Alarm,100000 Points,Loget260-THE
- Double data security: 1. Offline 100000 record points to prevent data loss, and will be uploaded after the network restores; 2. Support shadow data, real time temperature data recorder Loget260 allows you to forget to turn it on or mistakenly stop, which have still been recording during sudden situations.
- Multi-Source Sensing: Standard sensors: External Temperature(-40~85℃) / Humidity(0~100%RH) / Light(0~52000Lux) / Shock(0g~16g) / Location(LBS). Optional sensors: Humidity/PH value/CO2 Sensor.
- Remote Monitoring Via APP - Real-time data uploaded to Cloud platform via built-in 4G SIM card, upload interval settable(1 minutes to 24 hours). Cloud-based alarms can be received through Elitech iCold APP, SMS, Email, or platform. And including sound, screen, and indicator lights for offline alarm.
- Auto Flight mode/ Electronic Fence: Loget260 strives for aviation safety, complied with Do160. Custom area auto enable (Manual activation, Timed activation, Electronic fence). Loget260 can be widely used in Food Cold Chain, Harvest Management, Cold Chain Logistics, Insulation Box Matching and Life Science Market.
- Elitech iCold is a cloud-based remote accessible platform. It is compatible with RCW series products to realize real-time monitoring of cold chain data, automatic alerts and notifications, online data analysis and management. iCold helps users to achieve effective management of every step of cold chain and immediate assessent compliance. It complies with FDA CFR 21 Part 11 requirements and supports iOS and Android apps.
Quantity
-
Detail
-
Customer ReviewsNo comments